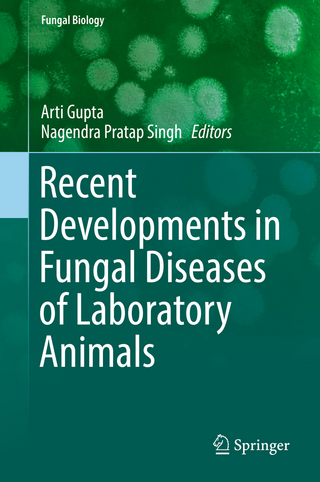
Recent Developments in Fungal Diseases of Laboratory Animals

The natural and human world of British fungi
Buch | Hardcover
2019
|
Bloomsbury Wildlife
ISBN: 9781472971494
CHF 63,90 (inkl. MwSt)
- Versand in
10-20 Tagen